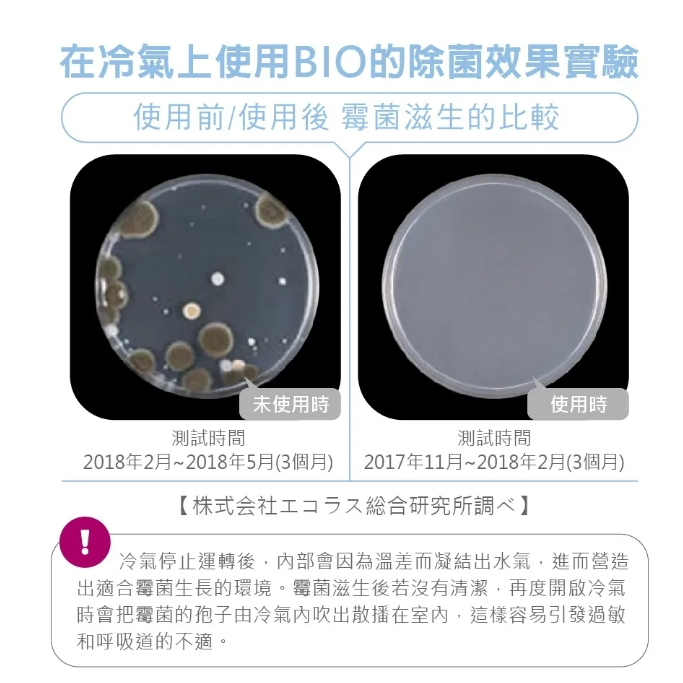
日本製 Cogit Power BIO 冷氣機 消臭防霉盒｜香港濕熱天氣必備！

客戶可先直接網站落單預留, 也可以whatsapp 55603677 或 Facebook PM 我們,謝謝~
++++++++++++++++++++++++++++++++++++++++
🔔 想第一時間收到最新優惠?
快啲加入我哋 WhatsApp 群組啦 👉
https://chat.whatsapp.com/CO9oxwx5KruHCHEVCnmleL
++++++++++++++++++++++++++++++++++++++++
🛍️ 貨期說明
- [現貨]:所有現貨商品將於收到訂單後 1-4 個工作日內寄出。
- [預購]:預購商品會在確認付款後約 7-20 日內到貨,但物流可能因各種因素有所延誤,敬請理解。
📦 運送與包裝注意事項
- 若選擇快遞寄送,我們會盡力做好包裝保護,但運送過程中可能出現碰撞情況,完美主義者請慎重考慮。
- 本店為代購性質,若遇供應商缺貨,將安排 全額退款。
💥 重要聲明
- ⭕️ 本產品為 平行進口正品。
- ⭕️ 本公司並未持有任何品牌之版權。
- ⭕️ 所有商標及版權均屬原品牌持有人。
- ⭕️ 圖片及資料僅供分享參考。
- ⭕️ 商品圖片可能與實物略有色差,請以實物為準。
⚠️ 盒裝產品購買須知
- 💢 運輸過程中可能導致外盒壓損、包裝有壓痕、開口不密合或無封膜,不影響產品內容與品質,請安心使用。
- 💢 運費將以 順豐最終收費為準。